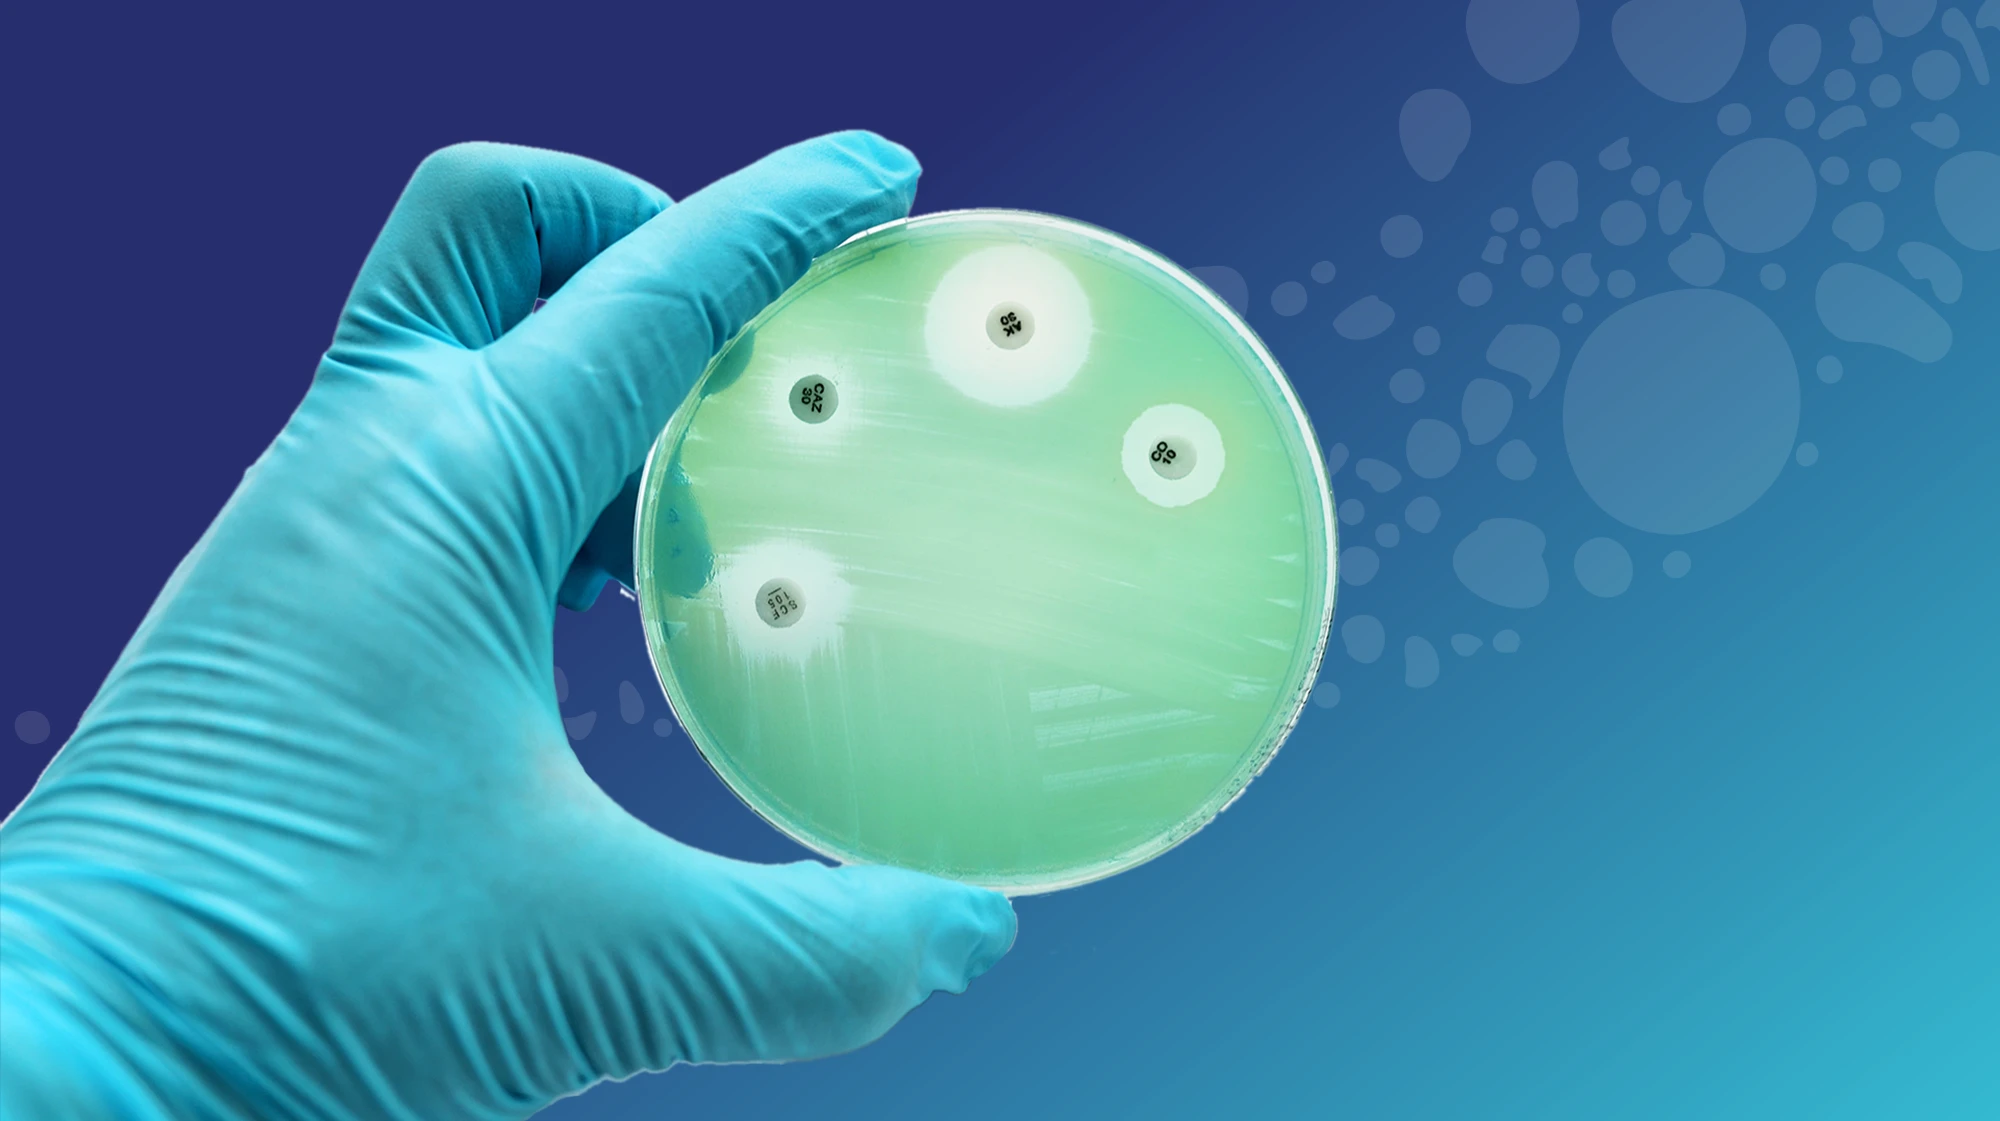

Discover
The AMR Action Fund is a groundbreaking $1 billion investment fund dedicated to combating antimicrobial resistance by bringing 2-4 new antibiotics to market by 2030. Despite its critical mission and unprecedented backing from 23 leading biopharmaceutical companies, the Fund faced the challenge of establishing itself as a credible force in an industry plagued by market failures and skepticism. With antibiotic development largely abandoned due to poor financial returns, the Fund needed to build immediate trust with biotech innovators, engage investors, and raise public awareness about the urgent threat of antimicrobial resistance.


Our team developed a comprehensive brand identity and multi-channel strategy that positioned the AMR Action Fund as a catalyst for change in the fight against superbugs. We created a bold visual identity and messaging framework that balanced scientific credibility with urgency, emphasizing the Fund's unique role in revitalizing the antibiotic pipeline. Our approach focused on building awareness across key stakeholder groups—from biotech companies seeking funding to policymakers and the general public who needed to understand why antimicrobial resistance poses a critical threat to global health.

We built an integrated marketing ecosystem that included a robust digital presence, thought leadership content, investor materials, and strategic event activations. Our social media strategy amplified the Fund's mission through educational content, partnership announcements, and compelling data visualizations that made the scale of the AMR crisis tangible. We developed materials for industry conferences and investor presentations that clearly articulated the Fund's investment thesis and portfolio approach, while creating content that brought human stories to the forefront of a complex scientific challenge.


The rebrand and integrated marketing approach successfully established the AMR Action Fund as a recognized leader in the antimicrobial resistance space. The Fund achieved significant media coverage and social media engagement, with growing awareness among target audiences about both the crisis and the solution. Industry stakeholders embraced the Fund's vision, leading to strong deal flow from biotech companies developing novel antibiotics. The comprehensive marketing foundation continues to support the Fund's mission, enabling ongoing stakeholder engagement as it works toward its goal of bringing life-saving antibiotics to patients.

.svg)